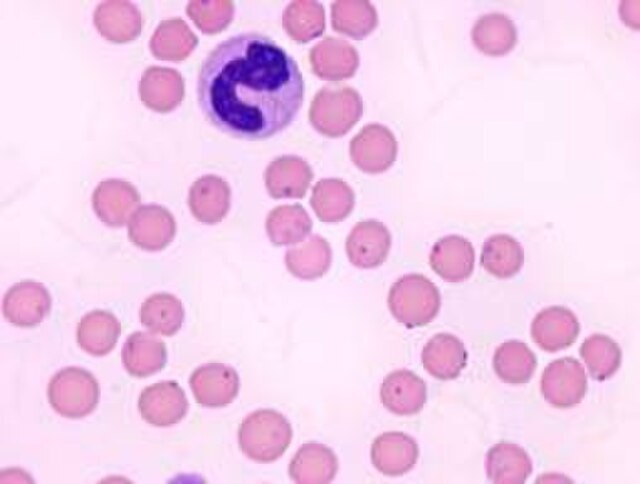
마이코플라즈마

반응형

마이코플라즈마 폐렴 유행!증상및 원인,예방법 정리
중국에서 마이코플라즈마 폐렴이 확산되면서 병원 병실이 부족할 정도로 상황이 심각하다는 뉴스가 보도되고 있습니다.
코로나19로 인해 고생좀 해 보았기에 괜스레 신경이 쓰이기도 합니다. 그래서 마이코플라즈마 폐렴이 어떤 질병인지 간단히 정리해 보겠습니다.
마이코플라즈마 폐렴의 원인
마이코플라즈마는 주로 땅속에 존재하고 동물과 식물에 기생하는 세균 이라고 합니다.
주로 호흡기로 감염이 되며,요로나 생식관을 통해 감염을 일으키기도 합니다.
마이코플라즈마는 불류칙한 구의 형태이며 세포벽이 없고 2~5μ정도의 크기 입니다.
마이코 플라스마는 마이코 플라즈마 제니탈리움, 마이코 플라즈마 호미니스, 마이코 플라스마균으로 크게 나눠집니다.
- 마이코플라즈마 폐렴은 호흡기를 통해서 전염이 될 수 있으며, 주로 날씨가 추워지는 가을과 겨울에 발생합니다. 호흡기 질환자에게는 매우 치명적인 질환이 될 수 있습니다.
- 마이코플라즈마 제니탈리움은 주로 성관계로 전염이 됩니다.
- 마이코플라즈마 호미니스는 성관계, 목욕탕, 수영장 등의 공용 시설에서도 감염될 수도 있습니다.
마이코플라즈마 폐렴의 증상
마이코플라즈마 폐렴은 연령층과 관계없이 누구나 전염될 수 있으며, 주로 5세~12세의 유아에게 많이 전염이 많이 되며 전염속도가 매우 빨라서 어린이집이나 학교등에서 의 발생률이 매우 높습니다.
- 잠복기:약 14일 정도의 잠복기를 거치며 보통 3년~4년의 주기로 유행합니다.
- 기침, 발열, 인후통, 피로감, 인후통등의 증상이 나타날 수 있습니다.
- 가벼운 증상이라도 제때 치료를 하지 않으면 심각한 호흡기 질환으로 악화될 수 있으며 합병증이 발생할 수 있습니다.
- 합병증:과민성 폐질환, 종이몀, 패혈증, 뇌수막염, 출농증 등
마이코프라즈마 폐렴의 치료
- 마이코프라즈마균은 세포벽이 없어서 특수 항생제를 사용하여 마이코프라즈마 폐렴 치료를 합니다.
- 주로 마크로라이드 계열의 항생제인 독시사이클린, 록시스로마이신, 클라리스로마이신, 아지스로마이신, 레보플록사신 등의 항생제를 사용하여 치료할 수 있습니다.
마이코프라즈마 폐렴의 예방
코로나 19 예방하는 방법과 같습니다.
- 대체적으로 코로나19와 비슷한 증상이 나타납니다. 발열 및 기침등의 증상이 있다면 병원에서 상담 및 검사를 받습니다.
- 개인위생 철저:기침, 재채기등을 할 때 입을 가리며, 손을 깨끗이 씻습니다.
- 손소독을 자주 해줍니다.
- 마스크를 착용해 줍니다.
마이코플라즈마 폐렴의 증상이 있을 시에는 병원을 방문하여 적절한 검사 및 치료를 받으시기를 바랍니다.
건강하세요!!!
반응형
'건강백과 > 건강관리' 카테고리의 다른 글
| 히트쇼크(heat shock) 발생 원인과 증상,예방,치료 방법 (0) | 2024.01.25 |
|---|---|
| 어깨 굳고 심한 통증 오십견,동결견 웃고 넘어갈 병 아닙니다. (0) | 2023.10.05 |
| 혈압약 없이 혈압 낮추는 방법 총 정리 (0) | 2023.02.13 |
댓글